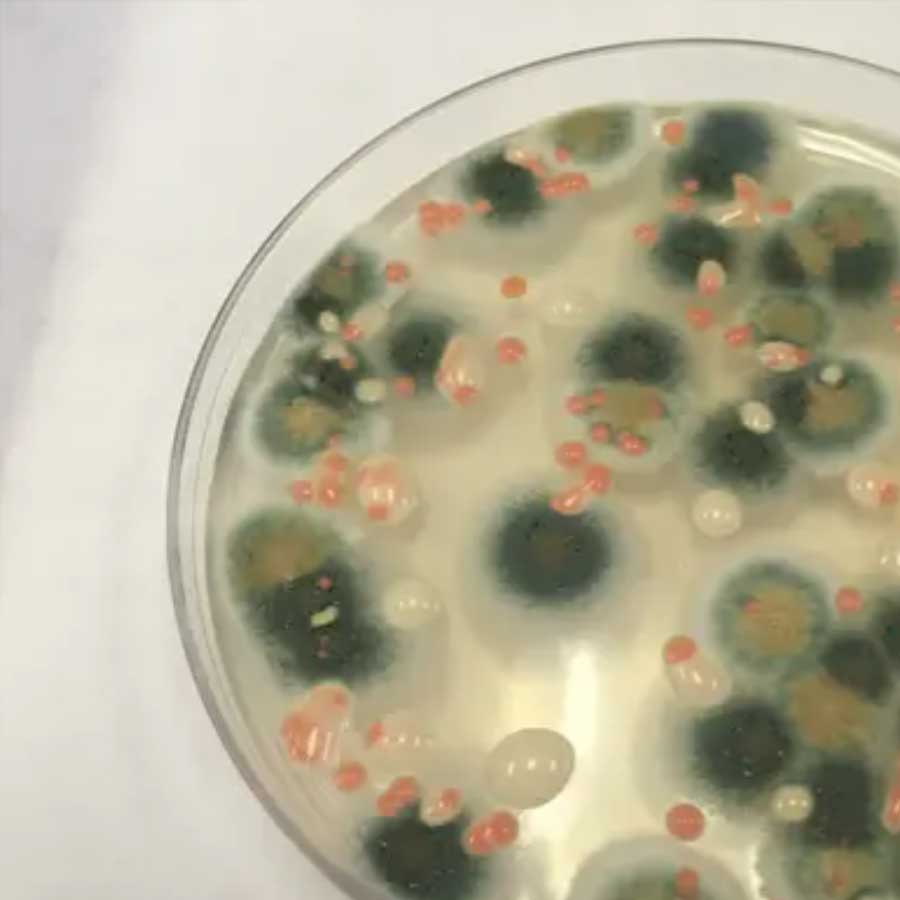
Mysterious fungus of Chernobyl

তেজস্ক্রিয়তা ‘খেয়ে’ শক্তি তৈরি করে চার দশক দিব্যি বেঁচে! চেরনোবিলের রহস্যময় ‘নীলকণ্ঠ’ই কি বাঁচাবে মহাকাশচারীদের?
উদ্ভিদকুল যেমন সালোকসংশ্লেষের জন্য সূর্যের আলোকে শক্তি হিসাবে গ্রহণ করে, তেমনই এই ছত্রাকটি শক্তির আধার হিসাবে তেজস্ক্রিয় বিকিরণ ‘গিলে খায়’। ১৯৯১ সালে রুশ গবেষক একাতেরিনা দাদাচোভার নেতৃত্বে গবেষকদের একটি দল খুঁজে পায় কালো রঙের অদ্ভুত এই ছত্রাকটিকে।


এখনও পর্যন্ত ইতিহাসের সবচেয়ে বড় পারমাণবিক দুর্ঘটনা। ১৯৮৬ সালের ২৬ এপ্রিলের মধ্যরাত। তৎকালীন সোভিয়েত ইউনিয়নের চেরনোবিল পারমাণবিক শক্তিকেন্দ্র কেঁপে ওঠে ভয়ঙ্কর বিস্ফোরণে। বিস্ফোরণের অভিঘাতে উড়ে যায় ২ হাজার টনের দরজা। হাজার বর্গ কিলোমিটারেরও বেশি এলাকা জুড়ে ধীরে ধীরে ছড়িয়ে পড়ে তেজস্ক্রিয় বিকিরণ।


বিষাক্ত বিকিরণের ফলে লাখো মানুষের জীবন বিপন্ন হয়। বিপর্যয়ে সব মিলিয়ে সরাসরি ক্ষতিগ্রস্ত হন সাড়ে ছ’লক্ষ মানুষ। এদের মধ্যে ছিল অগণিত শিশু। কেউ এক দিনের মধ্যে ঘটনাস্থলেই মারা যান। কারও ক্ষেত্রে বিকিরণের দগদগে ক্ষত ছড়িয়েছে পরবর্তী প্রজন্মেও। বিকিরণের জেরে পরবর্তী কালে ক্যানসারে মারা গিয়েছেন অন্তত ৯ হাজার অধিবাসী। বেসরকারি মতে সেই সংখ্যা আরও বেশি।


বিস্ফোরণের পর বন্ধ করে দেওয়া হয় পারমাণবিক কেন্দ্রটি। বিপর্যয়ের পর বিকিরণের ছোবল থেকে বাঁচাতে ১ লক্ষেরও বেশি বসবাসকারীকে সরিয়ে নেওয়া হয় এবং পারমাণবিক বিদ্যুৎকেন্দ্রের আশপাশের ৩০ কিলোমিটার ব্যাসার্ধ জুড়ে গড়ে তোলা হয় একটি বৃত্তাকার ‘এক্সক্লুশন জ়োন’। সেই এলাকা সম্পূর্ণ ভাবে মানববর্জিত।


প্রায় ৩৯ বছর কেটে যাওয়ার পরও ক্রমাগত বিকিরণ ঘটে চলেছে চেরনোবিলে, তেজস্ক্রিয়তার মাত্রা উচ্চ। তাই এই নির্দিষ্ট এলাকার মধ্যে মনুষ্য বসবাসের অনুমতি দেওয়া হয় না। এখানকার বাসিন্দা বলতে বন্য জীবজন্তু ও গাছপালা। পরিত্যক্ত এলাকাটি জীববিজ্ঞানী ও গবেষকদের কাছে হয়ে উঠেছে একটি গবেষণার খনি। বিজ্ঞানী বা গবেষকদের স্বল্প সময়ের জন্য এখানে প্রবেশের অনুমতি দেওয়া হয়। বিশেষ সুরক্ষা ও নিয়ম মানলে তবেই এখানে প্রবেশের ছাড়পত্র মেলে।


অনেক গবেষকই এই ভয়ঙ্কর দুনিয়ায় পা রাখেন তেজস্ক্রিয়তার প্রভাবগ্রস্ত জীবনের সন্ধান পেতে ও গবেষণা করতে। সেই গবেষণা চালাতে গিয়ে আশ্চর্য এক ছত্রাকের সন্ধান পান জীববিজ্ঞানীরা। কালো রঙের এই বিশেষ প্রজাতির ছত্রাক তেজস্ক্রিয় কণা খায়। ১৯৯১ সালে রুশ গবেষক একাতেরিনা দাদাচোভার নেতৃত্বে গবেষকদের একটি দল খুঁজে পায় কালো রঙের অদ্ভুত এই ছত্রাকটিকে।
আরও পড়ুন:


‘ক্ল্যাডোস্পোরিয়াম স্ফেরোস্পার্মাম’ নামের সেই মৃতজীবী বা পরজীবীটির সন্ধান মেলে পারমাণবিক চুল্লির ধ্বংসাবশেষ পরীক্ষা করার সময়। গবেষকদলটি চুল্লির প্রাচীরে ছত্রাকের উপস্থিতি আবিষ্কার করে। সেটিকে তুলে এনে গবেষণা করে দেখা গিয়েছে যে এই ছত্রাকটি কেবল বেঁচেই ছিল না, বেঁচে থাকার শক্তির উৎস হিসাবে এটি খায় তেজস্ক্রিয় বিকিরণ।


বিজ্ঞানীরা ৪ নম্বর চুল্লির দেওয়ালে কালো হয়ে যাওয়া একটি দাগ ক্রমশ বৃদ্ধি পেতে দেখেন। পরে পরীক্ষা করে গবেষকেরা সিদ্ধান্তে উপনীত হয়েছিলেন যে, যেখানে বিকিরণ সবচেয়ে বেশি ছিল সেখানেই সবচেয়ে বেশি বৃদ্ধি পেয়েছিল ছত্রাকটি। এই ছত্রাকটি এমন এক স্তরের বিকিরণের সঙ্গে নিজেকে খাপ খাইয়ে নিয়েছে যা বেশির ভাগ জীবের জন্য মারাত্মক।


উদ্ভিদকুল যেমন সালোকসংশ্লেষের জন্য সূর্যের আলোকে শক্তি হিসাবে গ্রহণ করে তেমনই এই ছত্রাকটি শক্তির আধার হিসাবে তেজস্ক্রিয় বিকিরণকে ‘গিলে’ খেয়ে বড় হয়। নিবিড় গবেষণার ফলে উঠে এসেছে যে, ছত্রাকগুলিতে একটি বিশেষ উপাদান উপস্থিত। সেটি হল মেলানিন।


মানুষের ত্বকে থাকে মেলানিন নামে রঞ্জক পদার্থ, যা ত্বকের স্বাভাবিক রং তৈরি করে। এই রঞ্জকের কমা বা বাড়ার উপরে ত্বকের রং নির্ভর করে। মেলানিন নিঃসরণ বাড়লে চামড়া কালো হয়ে যায়। মেলানিন অতিবেগনি বিকিরণ থেকে ত্বককে রক্ষা করে। ছত্রাকের ক্ষেত্রে এই মেলানিন একটু ভিন্ন ভাবে কাজ করে। এটি গামা বিকিরণকে রাসায়নিক শক্তিতে রূপান্তরিত করার জন্য মেলানিনকে ব্যবহার করে থাকে।
আরও পড়ুন:

এটি তেজস্ক্রিয় বিকিরণ শোষণ করে ব্যবহারযোগ্য শক্তিতে রূপান্তরিত করে বেঁচে থাকে। এর ফলে ছত্রাকটি উচ্চ মাত্রার তেজস্ক্রিয় অঞ্চলেও বহাল তবিয়তে বেঁচে থাকে। রেডিয়োসিন্থেসিসের কারণে পারমাণবিক বিকিরণের উপর নির্ভরশীল ক্ল্যাডোস্পোরিয়াম স্ফেরোস্পার্মাম ছত্রাক।


বিজ্ঞানীদের মতে, দীর্ঘ দিন বিষবায়ু সেবন করে ছত্রাকটি তেজস্ক্রিয়তার বিরুদ্ধে বর্মের মতো আচরণ করতে সক্ষম। তেজস্ক্রিয় বিকিরণের মাত্রা সহ্য করার ক্ষমতার জন্য এটি ভবিষ্যতে মহাকাশ গবেষণার ক্ষেত্রে যুগান্তকারী পরিবর্তন আনতে পারে বলে মনে করছেন মহাকাশ গবেষক ও জীববিজ্ঞানীরা।


তেজস্ক্রিয় বিকিরণ প্রতিরোধী হয়ে ওঠার ফলে জীবগুলিকে তেজস্ক্রিয় বর্জ্য পরিষ্কার করার জন্য ব্যবহার করা যেতে পারে। এর কার্যক্ষমতা পরীক্ষা করার জন্য মহাকাশ বিজ্ঞানীরা এক মাস ধরে আন্তর্জাতিক মহাকাশকেন্দ্রের ভিতরে ছত্রাকটি বৃদ্ধি করেছিলেন এবং বিকিরণ আটকানোর ক্ষমতা বিশ্লেষণ করেছিলেন।


সেই প্রাথমিক ফলাফল আশাব্যঞ্জক। মহাকাশের উচ্চমাত্রার বিকিরণ দীর্ঘমেয়াদি মহাকাশ অভিযানের জন্য একটি উল্লেখযোগ্য চ্যালেঞ্জ। কারণ, মহাজাগতিক বিকিরণের পরিমাণ বিজ্ঞানীদের নিরাপদে মহাকাশে পাঠানোর জন্য সবচেয়ে বড় বাধাগুলির মধ্যে একটি।


ক্ল্যাডোস্পোরিয়াম স্ফেরোস্পার্মামের মতো পরজীবীগুলিকে মহাকাশচারীদের সুরক্ষা দিতে, এমনকি মহাকাশের কেন্দ্রগুলিতে শক্তি উৎপাদনের জন্য সম্ভাব্য উপাদান হিসাবে ব্যবহার করা যেতে পারে বলে মনে করছেন গবেষকদের একাংশ।


চেরনোবিল ‘এক্সক্লুশন জ়োনে’ বসবাসকারী ছত্রাকেরা দীর্ঘ দিন বিষাক্ত পরিবেশে বেঁচে রয়েছে। এই অঞ্চলে টিকে থাকার ফলে এগুলির তেজস্ক্রিয় বিকিরণের মাত্রা সহ্য করার ক্ষমতা মানুষের তুলনায় বহু গুণ বেশি। এ ছাড়াও কম তাপমাত্রা, ঘন লবণাক্ত এবং চরম অম্ল জাতীয় পরিবেশ সহ্য করে টিকে থাকার অদ্ভুত ক্ষমতা রয়েছে এটির।


ক্ল্যাডোস্পোরিয়াম স্ফেরোস্পার্মামের মতো প্রজাতি দেখিয়েছে কী ভাবে বেঁচে থাকার প্রায় অসম্ভব পরিবেশেও খাপ খাইয়ে নিতে পারা সম্ভব। অত্যন্ত বিষাক্ত এবং দূষিত পরিবেশে মধ্যেও জীবনের অভিযোজন সফল করার প্রমাণ দিয়েছে এই বিকিরণখেকো ছত্রাক।







